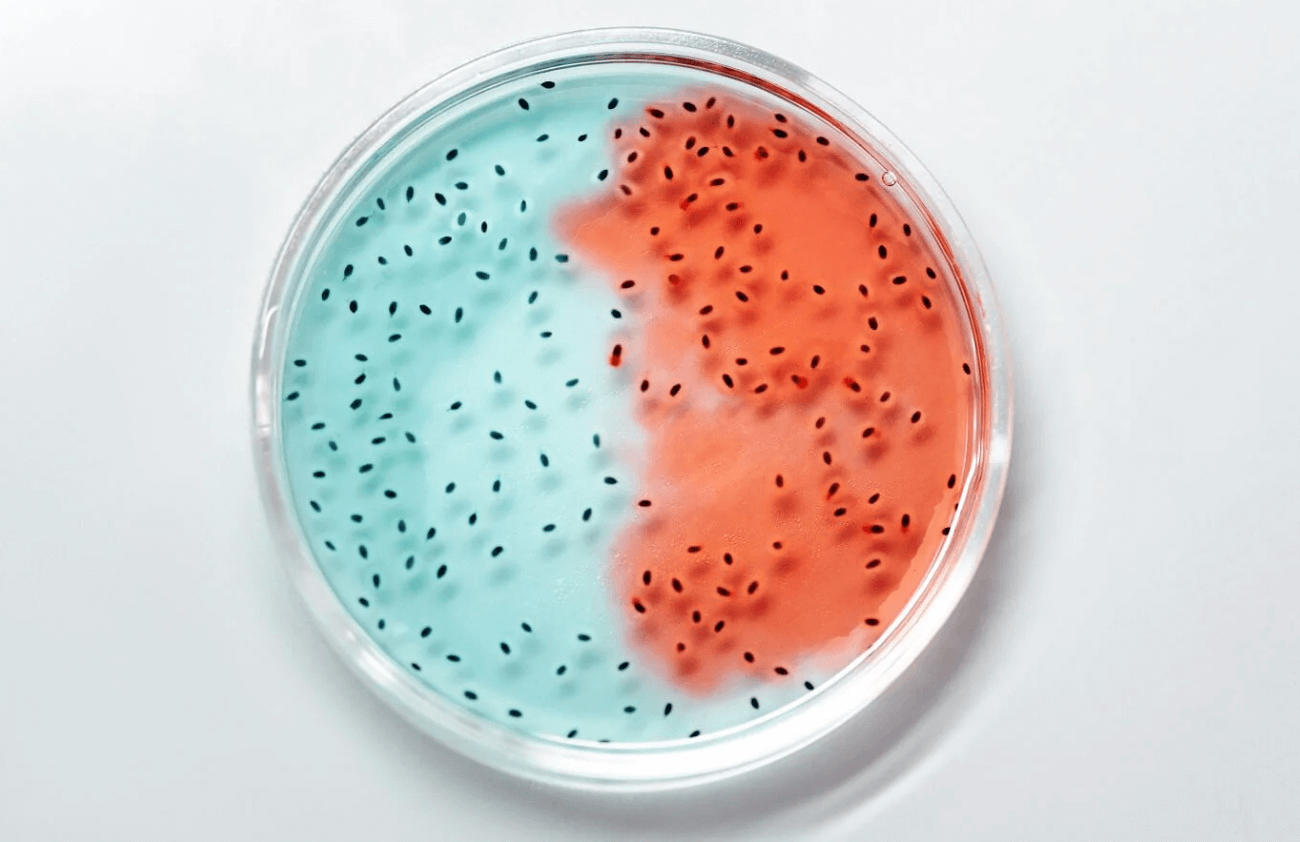
유산균 효과

다이어트 유산균 추천 속지말자 효과 없다
- 건강정보
- 2024. 5. 29. 21:21
다이어트 유산균 추천을 많은 사람들이 하고 있지만 실질적으로 효과가 있을까 대부분 해당 다이어트 유산균 제품을 받고 홍보하는 사람들의 글이 대부분이기 때문입니다. 개인적으로 다이어트 유산균 효과가 있다 없다를 떠나서 추천한거 먹어보고 별로 효과를 못 본 사람으로서 개인적 견해를 남겨 봅니다.

다이어트 유산균
날씨가 더워지면 본격적으로 다이어트에 돌입하는 여성들과 남성들이 많이 있습니다. 요즘 건강하게 다이어트를 할수 있다는 정보는 차고 넘치며, 그러한 정보중 다이어트 유산균에 대한 내용도 많이 나오곤 합니다.
그런데 이러한 다이어트 유산균이 그들이 말하는것 만큼 큰 효과가 있는지는 글세요 저는 잘 모르겠습니다. 그저 다이어트 유산균이나 일반 유산균이나 어떤 큰 차이가 있는지, 속에 들어가면 다 비슷한 것 같은데 말입니다.
솔직히 다이어트가 잘되기 위해서는 아침에 일어나서 화장실에 큰일을 보는것 만큼 효과적인 것이 없다고 봅니다. 그래서 많은 사람들이 변비에 걸리지 않고 장건강을 위해 유산균을 복용하는 것이지요.
즉 다이어트 유산균 이라는 말은 개인적으로 업체들이 만들어낸 말들이 아닐까 생각이 듭니다. 어찌 되었든 숙변을 하면 살이 빠지니 다이어트 유산균인 샘이니 간요. 이말 뜻을 이해하셨다면 그냥 유산균으로 접근하면 된다 생각이 듭니다.

다이어트 유산균 추천 속지 말자
요즘에는 광고나 너무 많고, 광고 업체에 제품을 받거나 원고료를 받고 써주는 블로그들이 너무나도 많기에 신뢰가 가지 않습니다. 쿠팡 후기 또한 체험단 제품을 받기 위해 정말 논문 적듯이 장대한 상품평을 적어놓은 글들을 보면, 과연 이런 극찬도 없습니다.
거기다가 대놓고 칭찬하는 게 눈치 보이니 단점이라 생각하는것 조금에 이러한 엄청난 장점을 소개하지요. 그런 포스팅을 보고 있으면 제대로 된 경험의 후기인지 그냥 뻔한 광고성 후기인지 혼란이 옵니다.
여러분은 후기를 볼 때 생각해야 합니다. 화가 났을 때 적는 후기를 중점으로 보시고, 칭찬 일색인 후기는 무조건 믿지 마시고 의심을 해봐야 합니다. 그럼에도 별이 낮은 후기는 상대편 업자일 수도 있지만 분노한 소비자일 가능성이 높기에 어떠한 문제점이 있는지를 먼저 별점이 낮은 후기를 보신 후 천천히 고민해 보시는 것도 넘쳐나는 정보의 바다에서 실수하지 않는 방법 중 하나라 생각합니다.
다이어트 유산균 효과
실질적으로 다이어트 유산균 효과를 보신 분들이 있나요. 네 저는 그래도 나름 다이어트 유산균이라고 구입해서 먹어봤는데 효과는 있었습니다. 늘 그랬듯 아침마다 화장실을 잘 가고 있기 때문입니다.
그러나 지금은 다이어트 유산균이라고 따로 구입하고 있지는 않으며, 그냥 유산균에 초첨을 맞추어 내장을 튼실하게 해 줄 수 있는 유산균 제품을 선택하고 있습니다.
요즘 국내에서 구입하는 유산균 제품들은 가격도 저렴하지 않은데, 1년 치 대량으로 구입하면 나름 가격 경쟁력이 있습니다. 다만 한번 구입할 때 몇십만 원을 지불하고 구입해야 해서 부담감을 가질 수도 있습니다.
1년치씩 한꺼번에 구입해서 복용하니 단점은 계속 먹다 보면 이게 좋은지 나쁜지 모릅니다. 그러다가 몸이 아파서 항생제를 먹는 경우 그동안 먹고 있던 유산균이 얼마나 가치가 있었는지 알게 되는, 순환을 거치고 있지요.
개인적 의견으로 다이어트 유산균 효과나 일반 유산균 제품 효과나 별반 차이가 없다고 생각하며, 판매하기 위한 광고 업체들의 신종 언어 또는 키워드에 속지 말고 제품의 본질을 이해합시다. 그러면 우리가 선택할 수 있는 제품들의 선택 범위가 넓어질 수 있습니다. 이상으로 다이어트 유산균 추천 속지 말자 효과 없다 포스팅을 줄입니다.
아차 글쓴이는 다이어트 유산균이라고 따로 복용하고 있지는 않지만 유산균은 매일매일 섭취하고 있습니다. 그래야 아침에 쾌변 할 수 있으니 간요.
▣ 유산균 추천
프로스랩 유산균 프리미엄 효능 후기
유산균이 우리몸에 얼마나 필요한 존재인지, 항생제를 복용하다 알게 되었으며, 이러한 유산균 또한 제품에 따라 상당한 질적인 차이가 있음을 느끼게 되었습니다. 일반적인 유산균을 먹다가
bluesmj.tistory.com
유산균 락토비프 추천 LactoBif
아침마다 화장실을 가는 것이 얼마나 행복한 것인지 매일 가다가 변비에 걸린 후 그 행복을 알았습니다. 장에 좋은 유산균 어떤 제품을 드시나요. 제가 추천해드리고 싶은 제품은 유산균 락토
bluesmj.tistory.com
BNR17 유산균 효능 부작용
나이가 들어감에 따라, 뱃살과 옆구리살에 대한 고민이 많아지고 있다. 솔직히 고민이라기 보다 포기상태이다. 젊을때는 분명 같은 양을 먹어도 해당부위가 저렇게 과할정도로 나오지 않았는데
bluesmj.tistory.com
'건강정보' 카테고리의 다른 글
| 기분이 우울할때 증상 기분전환 방법 (0) | 2024.06.21 |
|---|---|
| 다리 실핏줄 터짐 원인, 어떻게 되나요 (0) | 2024.06.18 |
| 무릎 줄기세포 주사 비용 가격 실손 청구 (0) | 2024.06.05 |
| 상악동 거상술 비용 뼈이식 가격 (0) | 2024.05.21 |
| 남자 왼쪽 아랫배 통증 내과 방문 후기 (2) | 2024.05.14 |
| 눈 비비면 망막열공 비문증 원인 (0) | 2024.05.08 |
| 파상풍 주사 가격 실비 보험 처리 (0) | 2024.05.04 |
이 글을 공유하기










